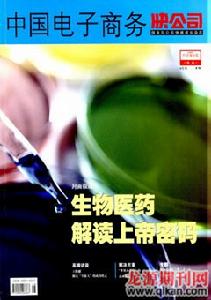
《中國電子商務》

《中國電子商務》
《中國電子商務》期刊信息
刊名:中國電子商務
英文刊名:DiscoveringValue
主管單位:中華人民共和國工業和信息化部
主辦單位:中國電子企業協會;中國電子器材公司
周期:月刊
出版地:北京市
語種:中文
開本:16開
ISSN:1009-4067
CN:11-4440/F
郵發代號:82-970
歷史沿革:
現用刊名:中國電子商務
創刊時間:2000
地址:北京市通州區翠景北里1號瑞都國際中心1911室中國電子商務雜誌社
郵編:101121
期刊級別:國家級期刊
雜誌介紹:
《中國電子商務》雜誌社是經國家新聞出版署批准,由國家工業與信息化部主管,中國電子企業協會主辦的國家級綜合性期刊。國內統一刊號:CN11-4440/F,國際標準連續出版物號:ISSN1009-4067,郵發代號82-970。創辦於2000年1月的《中國電子商務》,是國內第一本專注於全面研究國際、國內各行各業採用信息技術所帶來的商務新理念、經營新模式、管理新思維和市場新機遇的綜合性媒體。在中國已經進入數位化時代的今天,《中國電子商務》將攜手經濟領域和信息化領域的管理人員、科研開發人員、高校師生一起解讀信息化給中國經濟、管理、教育、醫療等方方面面帶來的進步和繁榮。
主要欄目:
信息化:信息科學、IT技術、網路技術、信息安全、電子商務、支付與結算、流通科技、案例分析、資料庫與資料庫管理經濟研究:國際經貿、物流論壇、商業研究、物流平台、供應鏈管理、資本運營、區域經濟、投資分析、產業經濟、網路行銷
企業管理:企業管理、經營管理、行銷策略、品牌戰略、市場調研、人力資源、企業文化、財務審計、財經論壇
教育及教學研究:教學研究、教育生活、課程與教學、教育信息化、信息化教學、科技研究等
投稿說明:
1、來稿一律使用WORD排版,來稿請註明作者姓名、單位、通訊地址、郵編、聯繫電話及電子信箱,建議用E-mail投稿。文章中計量單位以國家法定計量單位為準;各類符號須按照國家標準的規定書寫,參考文獻按引用的先後順序列於文末,圖片要清晰,註明圖號。2、來稿要具備一定的學術水平,保證文章著作權的獨立性、學術的嚴肅性,嚴禁抄襲,文責自負,請勿一稿多投,雜誌社審稿時間是3天,所有文章標題字數應在20字之內。來稿一般不超過5000字,一般論文及文稿2600字元。
3、本刊已加入萬方資料庫,維普期刊網,不願意通過網路媒體發布者,請在來稿中註明。
4、本刊編輯部對來稿有權修改。
5、本刊發表周期為20天,出刊5天內郵寄樣刊。
6、如有一稿多投、剽竊禍抄襲行為者,一切後果由作者本人負責。
7、摘要關鍵字題目中英文對照要齊全,超過一版的按1版半算,超過一版半按兩版算。
經濟財政類期刊大全(九)
| 從經濟學的意義來理解,財政是一個經濟範疇,財政作為一個經濟範疇,是一種以國家為主體的經濟行為,是政府集中一部分國民收入用於滿足公共需要的收支活動。 |

